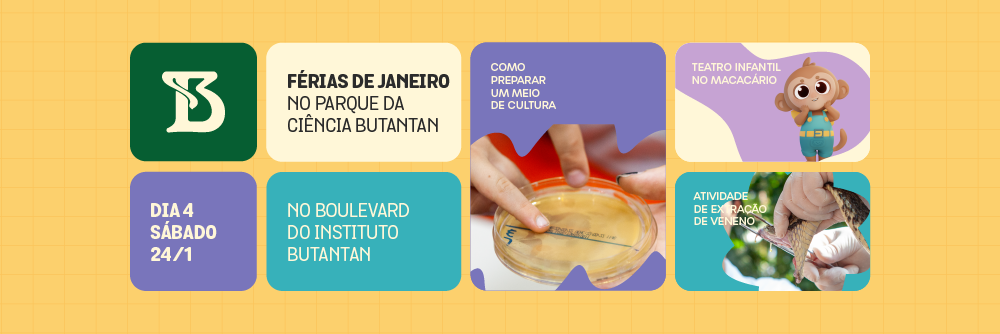
Arte com pequenos quadrados que mostram os destaques do quarto dia da programação de férias do Parque da Ciência

Publicado em: 30/12/2025
Que tal fazer uma divertida viagem no tempo nestas férias? Nos dias 21, 22, 23 e 24 de janeiro, o Parque da Ciência vai promover uma programação totalmente gratuita e recheada de atividades com o tema 125 anos do Instituto Butantan.
Como uma grande feira científica, museus, laboratórios e equipamentos culturais da instituição vão desenvolver atividades lúdicas, oficinas práticas e demonstrações educativas conduzidas por especialistas.
Spoilers da programação
O Museu da Vacina irá promover o jogo Uma viagem no tempo: 125 anos do Instituto Butantan, em que o público assume o papel de um viajante temporal explorando os primeiros dias da instituição. O público poderá participar, ainda, de atividades educativas sobre as Coleções Zoológicas.
O Museu de Microbiologia Professor Isaías Raw vai realizar a Visita Guiada – Lições da Peste, além da oficina Entre a Peste e o Butantan, relacionando a epidemia de Peste na Europa, a chegada da doença no Brasil e a criação do Instituto Butantan. Na atividade Museu Biológico vai ao Parque, os educadores da atração vão apresentar parte da coleção didática, composta por espécimes de serpentes, lagartos e aracnídeos preservados.
O Horto Oswaldo Cruz receberá a Sexta Animal Especial 125 anos de Instituto Butantan. A atividade será promovida pelos Museu Biológico e Museu Histórico, e abordará os principais cuidados para evitar acidentes ofídicos. Já o MUSPER promoverá a Roda da Saúde Climática, em que os participantes são desafiados a responder perguntas, realizar tarefas ou propor soluções criativas para problemas reais.
A programação de férias também vai ter uma Contação de Histórias sobre Emílio Ribas e Vital Brazil. No teatro de fantoches, voltado para crianças de 5 a 10 anos, os médicos sanitaristas contam como se tornaram grandes amigos e "detetives" da natureza.
Também integram a agenda especial atividades já tradicionais do Parque da Ciência, como a Extração de Veneno, promovida pelo Museu Biológico, e o Mão na Cobra, organizado pelo Laboratório de Ecologia e Evolução (LEEv).
Veja abaixo a programação completa, separada por dia, e organize sua visita ao Parque da Ciência Butantan!

| HORÁRIO | ATIVIDADE | DESCRIÇÃO | LOCAL | PÚBLICO |
| 9h às 16h45 | Uma viagem no tempo: 125 anos do Instituto Butantan | Por meio de um jogo online, o visitante percorrerá momentos históricos e participará de processos científicos que contribuíram para a construção da saúde pública e da educação científica no país | Museu da Vacina | A partir de 5 anos |
| 10h às 11h30 | Museu Biológico vai ao Parque | Apresentação de parte da coleção didática, composta por espécimes de serpentes, lagartos e aracnídeos preservados em via úmida e seca, réplicas táteis e materiais de divulgação | Tenda no Boulevard | Geral |
| 10h às 12h | Entre a Peste e o Butantan | Confecção de máscaras similares às utilizadas pelos médicos que trabalharam no combate da peste, além de montagem de cubeecraft de Vital Brazil | Tenda no Boulevard | A partir de 4 anos |
| 10h às 12h | Vacinação em Jogo | Jogos de tabuleiro e de cartas sobre vacinação e doenças imunopreveníveis | Tenda no Boulevard | A partir de 12 anos |
| 10h às 12h | Passatempos | Brincadeiras para aprender sobre vacinação e doenças que são preveníveis pela imunização | Tenda no Boulevard | A partir de 5 anos |
| 10h às 12h | Coleção Entomológica | Com base no acervo da coleção (insetos de interesse médico-veterinário preservados em via seca), a atividade apresenta a biologia, curiosidades e medidas de prevenção relacionadas a esses animais | Tenda no Boulevard | Geral |
| 10h às 12h | Coleção Herpetológica e o seu papel na conservação da biodiversidade e no avanço do conhecimento científico | Por meio de espécimes da coleção, a atividade evidencia a importância desses animais para a ciência, a riqueza da biodiversidade de répteis e anfíbios e a relevância de sua conservação, com ênfase nas serpentes | Tenda no Boulevard | Geral |
| 10h às 12h | Coleção Acarológica | Utilizando lâminas, frascos com espécimes e material educativo que ilustra o ciclo de vida de animais de importância médico-veterinária, a equipe apresenta as curiosidades e os cuidados relacionados a esses organismos | Tenda no Boulevard | Geral |
| 10h às 12h | Aracnídeos e miriápodes presentes na Coleção do Instituto Butantan | Apresentação de espécies da fauna brasileira de aracnídeos e miriápodes e suas curiosidades, abordando as estruturas anatômicas e desmistificando mitos sobre a periculosidade desses animais | Tenda no Boulevard | Geral |
| 10h às 12h | 125 anos de Ciência: sala multimídia com vídeos e publicações | Exibição de vídeos educativos da personagem Bubu e varal interativo com mensagens em homenagem ao aniversário do Butantan | Espaço de Leitura Infantojuvenil | Geral |
| 10h30 | Mão na cobra e outros bichos - Lagartos | Os visitantes poderão conhecer de perto algumas das espécies pesquisadas pelos cientistas do Instituto, refletindo sobre os impactos das ações humanas nesses animais. O agendamento deve ser feito a partir das 9h, na página da atividade. | Laboratório de Ecologia e Evolução | Geral (40 vagas) |
| 13h30 às 14h10 | Visita guiada - Lições da Peste | A atividade explora os aparatos expositivos do museu, relacionando-os com as epidemias de peste na Europa, a chegada da doença no Brasil e a criação do Instituto Butantan. Clique aqui para acessar o formulário de inscrição | Museu de Microbiologia Prof. Isaías Raw | Geral (15 pessoas) |
| 14h às 15h | Conhecendo a lagarta de fogo | O público é convidado a conhecer o fascinante trabalho realizado no Butantan com a lagarta Lonomia e entender a importância do soro antilonômico. Inscrições na recepção do museu | Museu Histórico - Espaço Terra Firme | Geral (15 pessoas) |
| 14h às 16h | 125 anos de Ciência: sala multimídia com vídeos e publicações | Exibição de vídeos educativos da personagem Bubu e varal interativo com mensagens em homenagem ao aniversário do Butantan | Espaço de Leitura Infantojuvenil | Geral |
| 14h às 16h | Instituto Butantan: entre o passado e o futuro | A oficina convida o público a criar histórias em quadrinhos projetando o futuro do Instituto Butantan daqui a 125 anos | Museu da Vacina | A partir de 5 anos (20 pessoas) |
| 14h30 às 15h10 | Preparação de meio de cultura | Os participantes aprendem a preparar meios de cultura para o cultivo de microrganismos e acompanham as etapas de aquecimento e distribuição em placas de Petri. Inscrições na recepção do Museu de Microbiologia, 30 minutos antes do início da atividade | Museu de Microbiologia Prof. Isaías Raw | A partir de 5 anos (20 pessoas) |
| 15h30 às 16h10 | Preparação de meio de cultura | Os participantes aprendem a preparar meios de cultura para o cultivo de microrganismos e acompanham as etapas de aquecimento e distribuição em placas de Petri. Inscrições na recepção do Museu de Microbiologia, 30 minutos antes do início da atividade | Museu de Microbiologia Prof. Isaías Raw | A partir de 5 anos (20 pessoas) |

| HORÁRIO | ATIVIDADE | DESCRIÇÃO | LOCAL | PÚBLICO |
| 9h às 16h45 | Uma viagem no tempo: 125 anos do Instituto Butantan | Por meio de um jogo online, o visitante percorrerá momentos históricos e participará de processos científicos que contribuíram para a construção da saúde pública e da educação científica no país | Museu da Vacina | A partir de 5 anos |
| 10h às 11h30 | Museu Biológico vai ao Parque | Apresentação de parte da coleção didática, composta por espécimes de serpentes, lagartos e aracnídeos preservados em via úmida e seca, réplicas táteis e materiais de divulgação | Tenda no Boulevard | Geral |
| 10h às 12h | Entre a Peste e o Butantan | Confecção de máscaras similares às utilizadas pelos médicos que trabalharam no combate da peste, além de montagem de cubeecraft de Vital Brazil | Tenda no Boulevard | A partir de 4 anos |
| 10h às 12h | Vacinação em Jogo | Jogos de tabuleiro e de cartas sobre vacinação e doenças imunopreveníveis | Tenda no Boulevard | A partir de 12 anos |
| 10h às 12h | Passatempos | Brincadeiras para aprender sobre vacinação e doenças que são preveníveis pela imunização | Tenda no Boulevard | A partir de 5 anos |
| 10h às 12h | Coleção Entomológica | Com base no acervo da coleção (insetos de interesse médico-veterinário preservados em via seca), a atividade apresenta a biologia, curiosidades e medidas de prevenção relacionadas a esses animais | Tenda no Boulevard | Geral |
| 10h às 12h | Coleção Herpetológica e o seu papel na conservação da biodiversidade e no avanço do conhecimento científico | Por meio de espécimes da coleção, a atividade evidencia a importância desses animais para a ciência, a riqueza da biodiversidade de répteis e anfíbios e a relevância de sua conservação, com ênfase nas serpentes | Tenda no Boulevard | Geral |
| 10h às 12h | Coleção Acarológica | Utilizando lâminas, frascos com espécimes e material educativo que ilustra o ciclo de vida de animais de importância médico-veterinária, a equipe apresenta as curiosidades e os cuidados relacionados a esses organismos | Tenda no Boulevard | Geral |
| 10h às 12h | Aracnídeos e miriápodes presentes na Coleção do Instituto Butantan | Apresentação de espécies da fauna brasileira de aracnídeos e miriápodes e suas curiosidades, abordando as estruturas anatômicas e desmistificando mitos sobre a periculosidade desses animais | Tenda no Boulevard | Geral |
| 10h às 12h | 125 anos de Ciência: sala multimídia com vídeos e publicações | Exibição de vídeos educativos da personagem Bubu e varal interativo com mensagens em homenagem ao aniversário do Butantan | Espaço de Leitura Infantojuvenil | Geral |
| 10h às 12h | MUSPER Goods | Os visitantes são convidados a colorir a história da saúde pública por meio de um livreto educativo inspirado na estética do fenômeno Bobbie Goods | Tenda no Boulevard | Geral |
| 10h30 | Mão na cobra e outros bichos - Serpentes | Os visitantes poderão conhecer de perto algumas das espécies pesquisadas pelos cientistas do Instituto, refletindo sobre os impactos das ações humanas nesses animais. O agendamento deve ser feito a partir das 9h, na página da atividade. | Laboratório de Ecologia e Evolução | Geral (40 vagas) |
| 13h30 às 14h10 | Visita guiada - Lições da Peste | A atividade explora os aparatos expositivos do museu, relacionando-os com as epidemias de peste na Europa, a chegada da doença no Brasil e a criação do Instituto Butantan. Clique aqui para acessar o formulário de inscrição | Museu de Microbiologia Prof. Isaías Raw | Geral (15 pessoas) |
| 14h às 15h | Carimbos de Serpentes: Arte e Ciência nas Escamas | Explore texturas de escamas de serpentes por meio de carimbos temáticos. Inscrições na recepção do museu | Museu Histórico - Espaço Terra Firme | Geral (15 pessoas) |
| 14h às 15h30 | Tabuleiro Gigante "Saúde em Jogo" | Os participantes poderão interagir com um tabuleiro gigante e entender como as mudanças climáticas influenciam na disseminação de doenças | Área externa do Museu da Vacina | A partir de 5 anos (4 pessoas por rodada) |
| 14h às 16h | 125 anos de Ciência: sala multimídia com vídeos e publicações | Exibição de vídeos educativos da personagem Bubu e varal interativo com mensagens em homenagem ao aniversário do Butantan | Espaço de Leitura Infantojuvenil | Geral |
| 14h às 16h | Exposição de mosquitos vetores | O público é convidado a conhecer os mosquitos vetores de doenças por meio de modelos didáticos, microscópios e larvas vivas | Pátio externo do Museu da vacina | Geral |
| 14h30 às 15h30 | Astros do Museu Biológico | Conheça alguns animais do Museu Biológico e os profissionais responsáveis pelos seus cuidados. Retirada de senhas a partir das 13h30, na Tenda no Boulevard | Tenda no Boulevard | Geral (50 pessoas) |

| HORÁRIO | ATIVIDADE | DESCRIÇÃO | LOCAL | PÚBLICO |
| 9h às 16h45 | Uma viagem no tempo: 125 anos do Instituto Butantan | Por meio de um jogo online, o visitante percorrerá momentos históricos e participará de processos científicos que contribuíram para a construção da saúde pública e da educação científica no país | Museu da Vacina | A partir de 5 anos |
| 10h às 11h30 | Museu Biológico vai ao Parque | Apresentação de parte da coleção didática, composta por espécimes de serpentes, lagartos e aracnídeos preservados em via úmida e seca, réplicas táteis e materiais de divulgação | Tenda no Boulevard | Geral |
| 10h às 12h | Entre a Peste e o Butantan | Confecção de máscaras similares às utilizadas pelos médicos que trabalharam no combate da peste, além de montagem de cubeecraft de Vital Brazil | Tenda no Boulevard | A partir de 4 anos |
| 10h às 12h | Vacinação em Jogo | Jogos de tabuleiro e de cartas sobre vacinação e doenças imunopreveníveis | Tenda no Boulevard | A partir de 12 anos |
| 10h às 12h | Passatempos | Brincadeiras para aprender sobre vacinação e doenças que são preveníveis pela imunização | Tenda no Boulevard | A partir de 5 anos |
| 10h às 12h | Coleção Entomológica | Com base no acervo da coleção (insetos de interesse médico-veterinário preservados em via seca), a atividade apresenta a biologia, curiosidades e medidas de prevenção relacionadas a esses animais | Tenda no Boulevard | Geral |
| 10h às 12h | Coleção Herpetológica e o seu papel na conservação da biodiversidade e no avanço do conhecimento científico | Por meio de espécimes da coleção, a atividade evidencia a importância desses animais para a ciência, a riqueza da biodiversidade de répteis e anfíbios e a relevância de sua conservação, com ênfase nas serpentes | Tenda no Boulevard | Geral |
| 10h às 12h | Coleção Acarológica | Utilizando lâminas, frascos com espécimes e material educativo que ilustra o ciclo de vida de animais de importância médico-veterinária, a equipe apresenta as curiosidades e os cuidados relacionados a esses organismos | Tenda no Boulevard | Geral |
| 10h às 12h | Aracnídeos e miriápodes presentes na Coleção do Instituto Butantan | Apresentação de espécies da fauna brasileira de aracnídeos e miriápodes e suas curiosidades, abordando as estruturas anatômicas e desmistificando mitos sobre a periculosidade desses animais | Tenda no Boulevard | Geral |
| 10h às 12h | 125 anos de Ciência: sala multimídia com vídeos e publicações | Exibição de vídeos educativos da personagem Bubu e varal interativo com mensagens em homenagem ao aniversário do Butantan | Espaço de Leitura Infantojuvenil | Geral |
| 10h às 12h | MUSPER Goods | Os visitantes são convidados a colorir a história da saúde pública por meio de um livreto educativo inspirado na estética do fenômeno Bobbie Goods | Tenda no Boulevard | Geral |
| 10h30 | Mão na cobra e outros bichos - Serpentes | Os visitantes poderão conhecer de perto algumas das espécies pesquisadas pelos cientistas do Instituto, refletindo sobre os impactos das ações humanas nesses animais. O agendamento deve ser feito a partir das 9h, na página da atividade. | Laboratório de Ecologia e Evolução | Geral (40 vagas) |
| 13h30 às 14h10 | Visita guiada - Lições da Peste | A atividade explora os aparatos expositivos do museu, relacionando-os com as epidemias de peste na Europa, a chegada da doença no Brasil e a criação do Instituto Butantan. Clique aqui para acessar o formulário de inscrição | Museu de Microbiologia Prof. Isaías Raw | Geral (15 pessoas) |
| 14h às 16h | Instituto Butantan: entre o passado e o futuro | A oficina convida o público a criar histórias em quadrinhos projetando o futuro do Instituto Butantan daqui a 125 anos | Museu da Vacina | A partir de 5 anos (20 pessoas) |
| 14h às 16h | 125 anos de Ciência: sala multimídia com vídeos e publicações | Exibição de vídeos educativos da personagem Bubu e varal interativo com mensagens em homenagem ao aniversário do Butantan | Espaço de Leitura Infantojuvenil | Geral |
| 14h às 16h | Roda da Saúde Climática | Ao girar uma roleta, cada participante é sorteado para responder uma pergunta, realizar uma tarefa ou propor soluções criativas para as mudanças climáticas | Tenda no Boulevard | Geral (4 pessoas por rodada) |
| 14h30 às 15h30 | Sexta Animal Especial de 125 anos do Instituto Butantan | Curiosidades e cuidados para evitar acidentes ofídicos. Retirada de senhas a partir das 13h, na Tenda no Boulevard | Teatro de Arena (Horto Oswaldo Cruz) | Geral (50 pessoas) |
| 15h às 16h | Descobrindo conchas: pesquisa e identificação de moluscos | O público é convidado a explorar informações sobre a coleta, indentificação e classificação de conhas. Inscrições no museu, 30 minutos antes do início da atividade | Deck do Museu de Microbiologia Prof. Isaías Raw | A partir de 4 anos (20 pessoas) |
| HORÁRIO | ATIVIDADE | DESCRIÇÃO | LOCAL | PÚBLICO |
| 9h às 16h45 | Uma viagem no tempo: 125 anos do Instituto Butantan | Por meio de um jogo online, o visitante percorrerá momentos históricos e participará de processos científicos que contribuíram para a construção da saúde pública e da educação científica no país | Museu da Vacina | A partir de 5 anos |
| 10h | Contação de Histórias - Emílio Ribas e Vital Brasil comemoram 125 anos do Instituto Butantan | Os fantoches de Emílio Ribas e Vital Brazil contam como se tornaram grandes amigos e “detetives” da natureza | Tenda no Boulevard | Crianças de 5 a 10 anos |
| 10h às 11h30 | Museu Biológico vai ao Parque | Apresentação de parte da coleção didática, composta por espécimes de serpentes, lagartos e aracnídeos preservados em via úmida e seca, réplicas táteis e materiais de divulgação | Tenda no Boulevard | Geral |
| 10h às 12h | Entre a Peste e o Butantan | Confecção de máscaras similares às utilizadas pelos médicos que trabalharam no combate da peste, além de montagem de cubeecraft de Vital Brazil | Tenda no Boulevard | A partir de 4 anos |
| 10h às 12h | Vacinação em Jogo | Jogos de tabuleiro e de cartas sobre vacinação e doenças imunopreveníveis | Tenda no Boulevard | A partir de 12 anos |
| 10h às 12h | Passatempos | Brincadeiras para aprender sobre vacinação e doenças que são preveníveis pela imunização | Tenda no Boulevard | A partir de 5 anos |
| 10h às 12h | 125 anos de Ciência: sala multimídia com vídeos e publicações | Exibição de vídeos educativos da personagem Bubu e varal interativo com mensagens em homenagem ao aniversário do Butantan | Espaço de Leitura Infantojuvenil | Geral |
| 10h30 | Conhecendo o LEEv: visita integrada | Os visitantes são convidados a conhecer as atividades e pesquisas desenvolvidas no Laboratório de Ecologia e Evolução do Instituto Butantan. O agendamento é disponibilizado às 9h do dia da atividade, no site do Parque da Ciência | Laboratório de Ecologia e Evolução | Geral (20 pessoas) |
| 10h30 | 125 anos do Butantan: A história do Macacário | O público infantil poderá conferir um teatro de curta duração (5 a 10 minutos) sobre a trajetória dos macacos rhesus no Butantan e seu papel vital para a saúde | Tenda em frente ao Macacário | A partir de 5 anos (8 crianças por mesa) |
| 10h45 | Contação de Histórias - Emílio Ribas e Vital Brasil comemoram 125 anos do Instituto Butantan | Os fantoches de Emílio Ribas e Vital Brazil contam como se tornaram grandes amigos e “detetives” da natureza | Tenda no Boulevard | Crianças de 5 a 10 anos |
| 11h30 | Contação de Histórias - Emílio Ribas e Vital Brasil comemoram 125 anos do Instituto Butantan | Os fantoches de Emílio Ribas e Vital Brazil contam como se tornaram grandes amigos e “detetives” da natureza | Tenda no Boulevard | Crianças de 5 a 10 anos |
| 14h às 15h | Visita Mediada – 125 anos de Instituto Butantan | Conheça a história do Butantan a partir de objetos, imagens e do edifício que abriga o Museu Histórico | Museu Histórico - Espaço Terra Firme | Geral (20 pessoas por sessão) |
| 14h às 15h30 | Tabuleiro Gigante "Saúde em Jogo" | Os participantes poderão interagir com um tabuleiro gigante e entender como as mudanças climáticas influenciam na disseminação de doenças | Área externa do Museu da Vacina | A partir de 5 anos (4 pessoas por rodada) |
| 14h às 16h | 125 anos de Ciência: sala multimídia com vídeos e publicações | Exibição de vídeos educativos da personagem Bubu e varal interativo com mensagens em homenagem ao aniversário do Butantan | Espaço de Leitura Infantojuvenil | Geral |
| 14h30 às 15h30 | Extração de Veneno | Demonstração de extração de veneno e a importância das serpentes para o meio ambiente. Retirada de senhas a partir das 13h30, na Tenda no Boulevard | Teatro de Arena (Horto Oswaldo Cruz) | Geral (100 pessoas) |
| 14h30 | 125 anos do Butantan: A história do Macacário | O público infantil poderá conferir um teatro de curta duração (5 a 10 minutos) sobre a trajetória dos macacos rhesus no Butantan e seu papel vital para a saúde | Tenda em frente ao Macacário | A partir de 5 anos (8 crianças por mesa) |
| 14h30 às 15h10 | Preparação de meio de cultura | Os participantes irão aprender a preparar meios de cultura para o cultivo de microrganismos e acompanharão as etapas de aquecimento e distribuição em placas de Petri. Inscrições na recepção do Museu de Microbiologia, 30 minutos antes do início da atividade | Museu de Microbiologia Prof. Isaías Raw | A partir de 5 anos (20 pessoas) |
| 15h | Conhecendo o LEEv: visita integrada | Os visitantes são convidados a conhecer as atividades e pesquisas desenvolvidas no Laboratório de Ecologia e Evolução do Instituto Butantan. O agendamento é disponibilizado às 9h do dia da atividade, no site do Parque da Ciência | Laboratório de Ecologia e Evolução | Geral (20 pessoas) |
| 15h30 às 16h10 | Preparação de meio de cultura | Os participantes irão aprender a preparar meios de cultura para o cultivo de microrganismos e acompanharão as etapas de aquecimento e distribuição em placas de Petri. Inscrições na recepção do Museu de Microbiologia, 30 minutos antes do início da atividade | Museu de Microbiologia Prof. Isaías Raw | A partir de 5 anos (20 pessoas) |
Serviço
Férias no Butantan – 2026
Dias: 21, 22, 23 e 24 de janeiro
Horário: das 10h às 16h
Endereço: Av. Vital Brasil, 1.500 - Butantã, São Paulo - SP, 05503-900